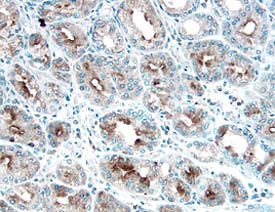
Gas6 antibody in Human Stomach Cancer Tissue by Immunohistochemistry (IHC-P).

Human Gas6 Antibody
R&D Systems, part of Bio-Techne | Catalog # AF885


Key Product Details
Validated by
Species Reactivity
Validated:
Cited:
Applications
Validated:
Cited:
Label
Antibody Source
Product Specifications
Immunogen
Asp118-Ala678
Accession # NP_000811
Specificity
Clonality
Host
Isotype
Scientific Data Images for Human Gas6 Antibody
Detection of Human Gas6 by Western Blot.
Western blot shows lysates of SH-SY5Y human neuroblastoma cell line, SW480 human colorectal adenocarcinoma cell line, COLO 205 human colorectal adenocarcinoma cell line, and human intestine tissue. PVDF membrane was probed with 1 µg/mL of Goat Anti-Human Gas6 Antigen Affinity-purified Polyclonal Antibody (Catalog # AF885) followed by HRP-conjugated Anti-Goat IgG Secondary Antibody (Catalog # HAF109). Specific bands were detected for Gas6 at approximately 64 and 50 kDa (as indicated). This experiment was conducted under reducing conditions and using Immunoblot Buffer Group 1.Gas6 in Human Stomach Cancer Tissue.
Gas6 was detected in immersion fixed paraffin-embedded sections of human stomach cancer tissue using 10 µg/mL Goat Anti-Human Gas6 Antigen Affinity-purified Polyclonal Antibody (Catalog # AF885) overnight at 4 °C. Before incubation with the primary antibody tissue was subjected to heat-induced epitope retrieval using Antigen Retrieval Reagent-Basic (Catalog # CTS013). Tissue was stained with the Anti-Goat HRP-DAB Cell & Tissue Staining Kit (brown; Catalog # CTS008) and counterstained with hematoxylin (blue). View our protocol for Chromogenic IHC Staining of Paraffin-embedded Tissue Sections.Detection of Human Gas6 by Western Blot
Migration of H1299 NSCLC cells enhanced by ligand-dependent Axl activation. (A) Western blotting to assess Gas6 expression in H1299 cells. Expression of Gas6 in LCAFhTERT cells was used as a positive control. (B) Phosphorylation of Axl was analyzed by Western blotting of whole cell lysates using different antibodies. GAPDH was used as an internal control. H1299 cells were stimulated for 15 min with 400 nM recombinant human Gas6 (rGas6). H1299 cells were treated with or without TP-0903 (0.2 µmol/L) for 24 h. (C) Migration of H1299 cells was analyzed using rGas6 (400 nM) added to the lower chamber. H1299 cells were treated with or without TP-0903 (0.2 µmol/L) for 24 h. (D) Western blotting of conditioned medium from LCAFhTERT transfected with siGas6 or siScr (control) to assess whether they contains Gas6 secreted by CAFs. (E) Phosphorylation of Axl in H1299 cells analyzed by Western blotting after stimulation with conditioned medium from siRNA-transfected LCAFhTERT. H1299 cells were treated with or without TP-0903 (0.2 µmol/L) for 24 h. The medium (DMEM containing 10% FBS) was used as control. (F) Migration of H1299 cells analyzed using conditioned medium of siRNA-transfected LCAFhTERT. H1299 cells were treated with or without TP-0903 (0.2 µmol/L) for 24 h. The medium (DMEM containing 10% FBS) was used as control. The relative number of migrated H1299 cells is indicated on the y-axis. Data show the mean ± SEM (n = 3); **p < 0.01. Image collected and cropped by CiteAb from the following open publication (https://pubmed.ncbi.nlm.nih.gov/28878389), licensed under a CC-BY license. Not internally tested by R&D Systems.Applications for Human Gas6 Antibody
ELISA
This antibody functions as an ELISA detection antibody when paired with Mouse Anti-Human Gas6 Monoclonal Antibody (Catalog # MAB8851), Mouse Anti-Human Gas6 Monoclonal Antibody (Catalog # MAB8852) or Mouse Anti-Human Gas6 Monoclonal Antibody (Catalog # MAB8853).
This product is intended for assay development on various assay platforms requiring antibody pairs. We recommend the Human Gas6 DuoSet ELISA Kit (Catalog # DY885B) for convenient development of a sandwich ELISA.
Immunohistochemistry
Sample: Immersion fixed paraffin-embedded sections of human stomach cancer tissue subjected to Antigen Retrieval Reagent-Basic (Catalog # CTS013)
Western Blot
Sample: SH‑SY5Y human neuroblastoma cell line, SW480 human colorectal adenocarcinoma cell line, COLO 205 human colorectal adenocarcinoma cell line, and human intestine tissue
Formulation, Preparation, and Storage
Purification
Reconstitution
Formulation
Shipping
Stability & Storage
- 12 months from date of receipt, -20 to -70 °C as supplied.
- 1 month, 2 to 8 °C under sterile conditions after reconstitution.
- 6 months, -20 to -70 °C under sterile conditions after reconstitution.
Background: Gas6
Gas6 (Growth Arrest Specific 6) is a multimodular protein that is upregulated by a wide variety of cell types in response to growth arrest (1). Gas6 and the structurally related Protein S are vitamin K-dependent and have an extensively gamma-carboxylated N-terminal Gla domain, four EGF-like repeats, and a C-terminal region with homology to steroid hormone binding globulin (SHBG) (2). Human Gas6 is a 75 kDa protein that shares 77-79% amino acid (aa) sequence identity with mouse and rat Gas6 and 43% aa sequence identity with human protein S (over the region expressed). Alternate splicing generates isoforms that lack the Gla domain and/or the spacer between the EGF-like and SHBG regions. Gas6 binds and induces signaling through the receptor tyrosine kinases Axl, Dtk, and Mer (3-5). Human Gas6 interacts with both mouse and rat orthologs of these receptors (1). The full length isoform may be cleaved, resulting in release of the free SHBG region which can independently activate Axl (6). Shed soluble forms of Axl and Mer bind Gas6 and function as decoy receptors (7, 8). Gas6 induces a variety of responses, including prevention of apoptosis (9), cell proliferation (10), platelet-mediated thrombosis (11), retinal epithelial cell phagocytosis of outer rod segments (12), inhibition of VEGF‑induced endothelial cell chemotaxis (13), and the differentiation and expansion of NK cell precursors (14). The affinity of Gas6 for phosphatidylserine likely contributes to its role in promoting the phagocytosis of apoptotic cells (15). Several of these effects have been shown to require gamma-carboxylation of the Gla domain (12, 16).
References
- Hafizi, S. and B. Dahlback (2006) FEBS J. 273:5231.
- Manfioletti, G. et al. (1993) Mol. Cell Biol. 13:4976.
- Stitt, T.N. et al. (1995) Cell 80:661.
- Ohashi, K. et al. (1995) J. Biol. Chem. 270:22681.
- Nagata, K. et al. (1996) J. Biol. Chem. 271:30022.
- Goruppi, S. et al. (1997) FEBS Lett. 415:59.
- Sather, S. et al. (2007) Blood 109:1026.
- Budagian, V. et al. (2005) Mol. Cell. Biol. 25:9324.
- Shankar, S.L. et al. (2006) J. Neurosci. 26:5638.
- Yanagita, M. et al. (2002) J. Clin. Invest. 110:239.
- Gould, W.R. et al. (2005) J. Thromb. Haemost. 3:733.
- Hall, M.O. et al. (2002) Exp. Eye Res. 75:391.
- Gallicchio, M. et al. (2005) Blood 105:1970.
- Caraux, A. et al. (2006) Nat. Immunol. 7:747.
- Wu, Y. et al. (2005) J. Cell Sci. 118:539.
- Hasanbasic, I. et al. (2005) J. Thromb. Haemost. 3:2790.
Long Name
Alternate Names
Gene Symbol
UniProt
Additional Gas6 Products
Product Documents for Human Gas6 Antibody
Product Specific Notices for Human Gas6 Antibody
For research use only